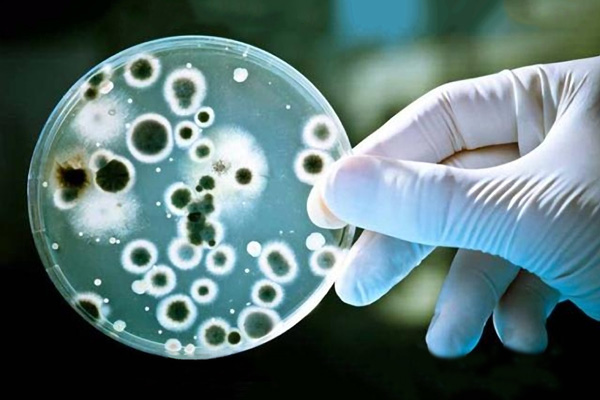

Kandida kod muškaraca
Kandidijaza kod muškaraca simptomi, uzrok, lečenje
Kandida kod muškaraca, iako ne tako često kao kod žena, može dovesti do gljivične genitalne infekcije, odnosno genitalne kandidijaze. Razmnožavanju kandide naročito pogoduje vlažna sredina, pa se često može naći u genitalnoj regiji. Kandida kod muškaraca može izazvati zapaljenje glavića penisa i prepucijuma (okolne kože). Pored genitalija kandidijaza se kod muškaraca može javiti i na drugim mestima prekrivenim kožom ili sluzokožom, na primer u ustima. Često je genitalna kandidijaza samo spoljašnja manifestacija prekomernog rasta kandide u crevima.
Muškarci su često asimptomatski prenosioci, imaju kandidu, ali nemaju simptome. Iako kandida ne spada u polno prenosive bolesti može se preneti sa jednog na drugog partnera.
Kandida kod muškaraca simptomi
Neki od simptoma genitalne kandidijaze kod muškaraca mogu biti: crvenilo, osip, otok, bol i iritacija, svrab, bele fleke, bol pri seksualnom odnosu ili uriniranju. Važno je naglasiti da je kandida kod muškaraca obično bez simptoma.
Genitalna kandidijaza se često javlja zajedno sa crevnom kandidijazom. Simptomi crevne kandidijaze su: nadutost stomaka, podrigivanje, dijareja ili opstipacija, bolovi ili grčevi u stomaku. Kandida otpušta preko 70 jedinjenja, uključujući i neke neurotoksine, pa simptomi crevne kandidijaze mogu biti i razdražljivost, hroničan umor, depresija ili anksioznost, fibromialgija, preosetljivost na svetlo…
Candida kod muškaraca uzrok
Kandida je normalno prisutna kod muškaraca, ali dejstvom sledećih faktora dolazi do uništavanja normalne flore, što pogoduje preteranom rastu kandide i pojavi kandidijaze:
- Antibiotici širokog spektra uništavaju normalnu bakterijsku floru, a to narušava balans i dovodi do širenja kandide.
- Lekovi koji slabe imuni sistem, kao što su kortikosteroidi ili hemoterapija.
- Oslabljen imunitet usled stresa ii bolesti
- Dijabetes, naročito ako se ne kontroliše
- Kandida kod muškaraca češće izaziva infekcije ukoliko nisu obrezani, jer vlažan i topao prostor ispod kožice pogoduje rastu gljivica.
- Lična higijena – konstantna iritacija sredstvima za higijenu (kupke za tuširanje, alkalni sapuni, lubrikanti) dovodi do oštećenja normalne flore, pa je infekcija kandidom češća. Takođe, ukoliko se nakon tuširanja pažljivo ne osuši penis, stvara se sredina pogodna za razvoj kandide.
- Loša ishrana
- Dijaliza bubrega
Da li se kandida može preneti sa žene na muškarca?
Kandida kod muškaraca se može javiti posle seksualnog odnosa sa ženom koja ima kandidijazu. Ipak, kandidijaza se ne smatra seksualno prenosivom bolešću, jer se može javiti i kod muškaraca koji nemaju seksualne odnose. Muškarci čije partnerke imaju genitalne gljivične infekcije, ne moraju imati kandidu, jer seksualni odnos ne mora dovesti do gljivične infekcije. Međutim, savetuje se korišćenje zaštite prilikom seksualnog odnosa.
Kandida kod muškaraca komplikacije
Kandidijaza kod muškaraca može dovesti i do komplikovanijih stanja koja zahtevaju hitne intervencije. U slučaju oslabljenog imunog sistema, može doći do širenja kandide u krvotok, putem koje se brzo prenosi do svih delova tela. Ovo je ozbiljna infekcija, koja može biti fatalna. Faktori rizika koji dovode do nastanka invazivne kandidijaze su:
- HIV infekcija
- Dijabetes
- Imunosupresivni lekovi (kod transplantacije)
- Visoke doze hemoterapije ili radioterapije
- Korišćenje centralnog venskog katetera
- Dijaliza
Kandida kod muškarca i anti kandida program sa Reishiperna sirupom i Otporil kapima
Reishiperna sirup i Otporil kapi su potpuno prirodni preparati atestirani na VMA i Farmaceutskom fakultetu u Beogradu.

Reishiperna sirup i Otporil kapi:
- Eliminišu kandidu zahvaljujući prirodnim antimikoticima iz reishi, propolisa, belog luka i lekovitog bilja
- Jačaju imunitet zahvaljujući prirodnim imunostimulatorima i imunomodulatorima (reishi, propolis, beli luk)
- Čiste organizam od štetnih toksina (reishi, kopriva, ekstrakt borovnice)
- Vrše regeneraciju sluzokože digestivnog i urogenitalnog trakta (kantarion, hajdučka trava, nana, anis, kamilica)
- Predstavljaju prirodni multivitamin. Sadrže vitamin C, vitamin A, vitamin E, kalcijum, kalijum, magnezijum, gvožđe, cink, selen, bakar, kobalt, aminokiseline, fitonutrijente, antioksidanse i omega-3 masne kiseline iz novozelandske zelenousne školjke
Više o tome kako deluju ovi prirodni preparati možete da pročitate ovde:

ANTI KANDIDA PLUS KOMPLET – kliknite ovde

ORALNA KANDIDA PLUS KOMPLET – kliknite ovde
Ovde možete uraditi test kojim se proverava nivo kandide u organizmu. Da li će se uticaj kandide proširiti i na druge organe zavisi upravo od količine kandide.
Testirajte se: